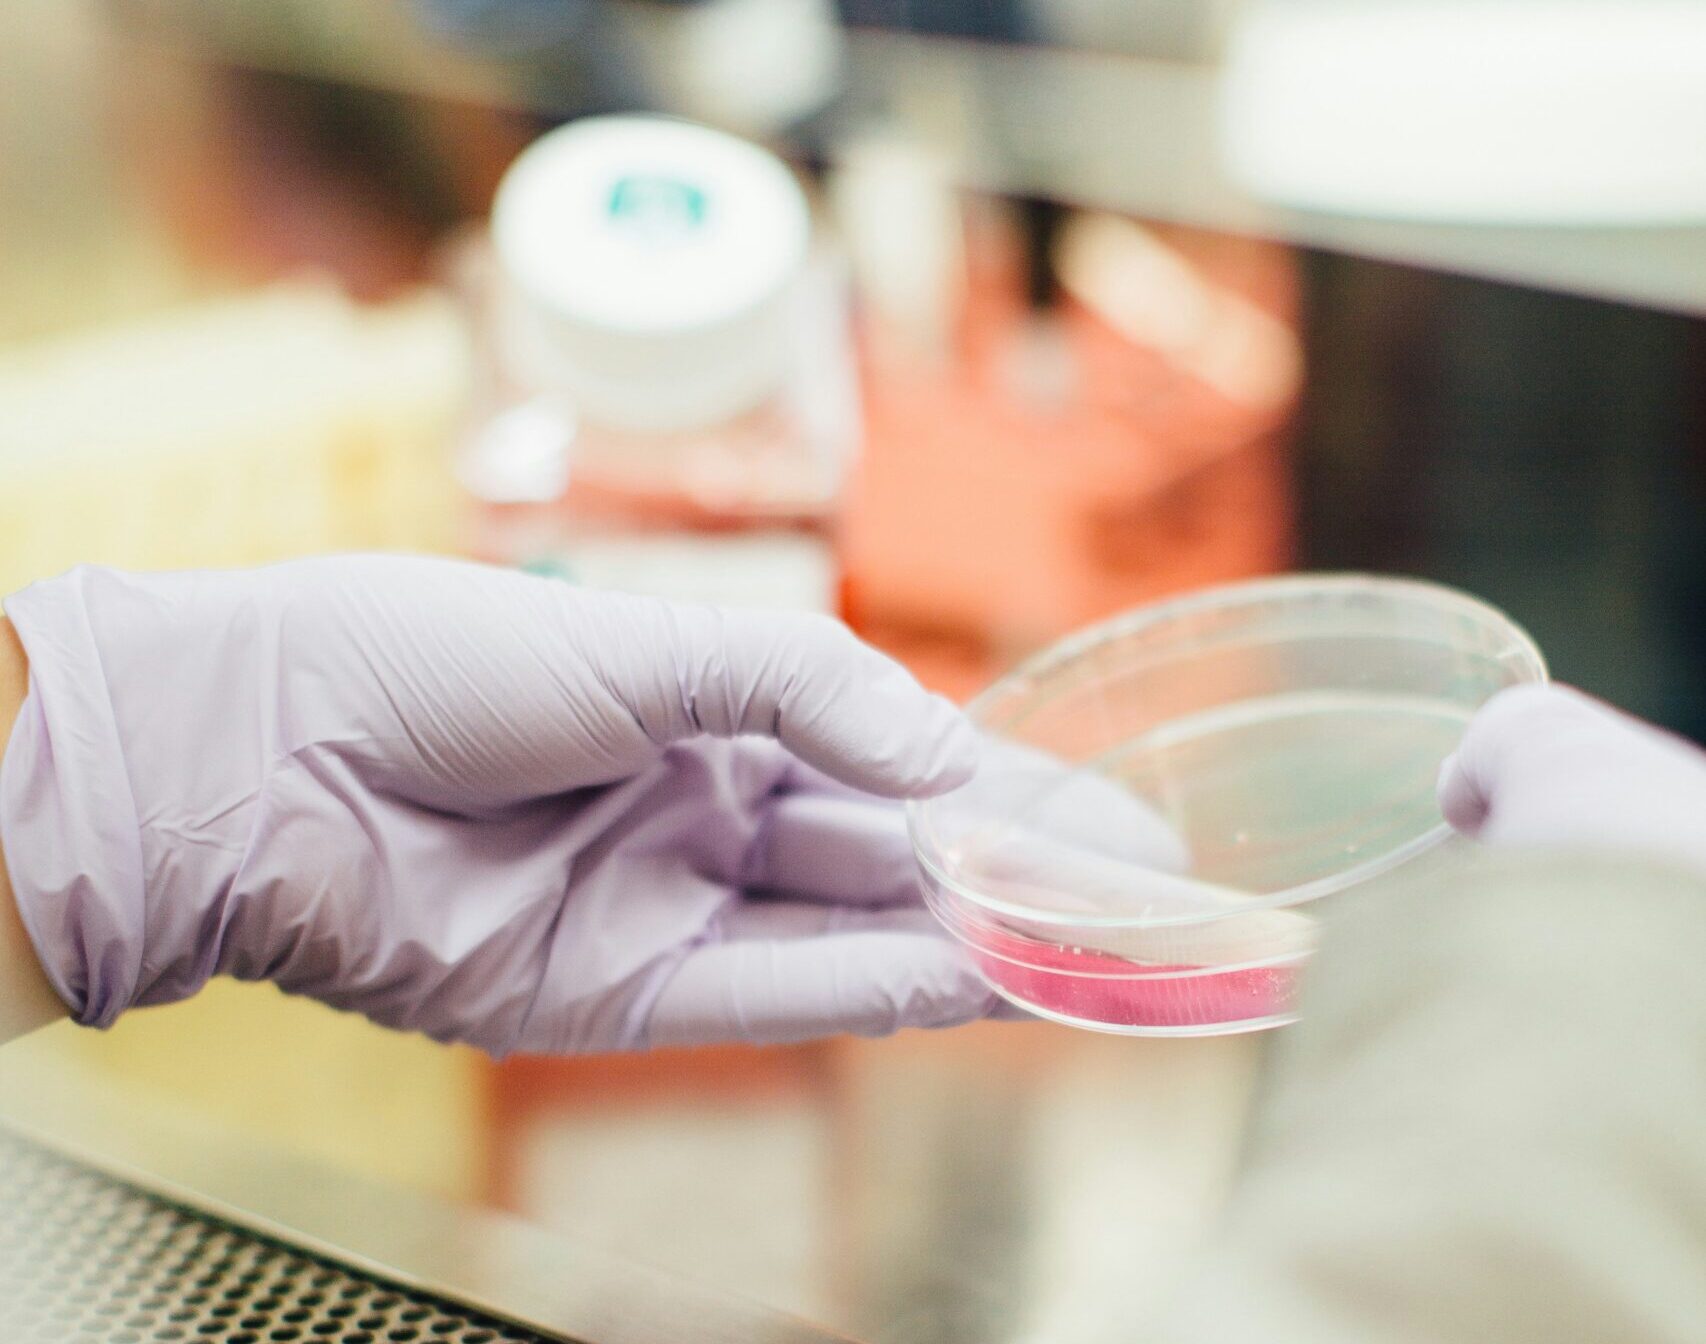

International Conference on Molecular Targets and Cancer Therapeutics
Boston, Massachusetts, United StatesOctober 22-26, 2025 Boston, Massachusetts, United States
 Cancer Stem Cell News
Cancer Stem Cell News Cell Therapy News
Cell Therapy News Dermal Cell News
Dermal Cell News Endothelial Cell News
Endothelial Cell News ESC & iPSC News
ESC & iPSC News Extracellular Matrix News
Extracellular Matrix News Hematopoiesis News
Hematopoiesis News Hepatic Cell News
Hepatic Cell News Human Immunology News
Human Immunology News Immune Regulation News
Immune Regulation News
 Intestinal Cell News
Intestinal Cell News Mammary Cell News
Mammary Cell News Mesenchymal Cell News
Mesenchymal Cell News Muscle Cell News
Muscle Cell News Neural Cell News
Neural Cell News Organoid News
Organoid News Pancreatic Cell News
Pancreatic Cell News Prostate Cell News
Prostate Cell News Pulmonary Cell News
Pulmonary Cell News Cancer Stem Cell News
Cancer Stem Cell News Cell Therapy News
Cell Therapy News Dermal Cell News
Dermal Cell News Endothelial Cell News
Endothelial Cell News ESC & iPSC News
ESC & iPSC News Extracellular Matrix News
Extracellular Matrix News Hematopoiesis News
Hematopoiesis News Hepatic Cell News
Hepatic Cell News Human Immunology News
Human Immunology News Immune Regulation News
Immune Regulation News
 Intestinal Cell News
Intestinal Cell News Mammary Cell News
Mammary Cell News Mesenchymal Cell News
Mesenchymal Cell News Muscle Cell News
Muscle Cell News Neural Cell News
Neural Cell News Organoid News
Organoid News Pancreatic Cell News
Pancreatic Cell News Prostate Cell News
Prostate Cell News Pulmonary Cell News
Pulmonary Cell News
October 22-26, 2025 Boston, Massachusetts, United States

October 31-November 3, 2025 Riviera Maya, Mexico

November 2-4, 2025 Sitges, Spain

November 5-7, 2025 Singapore

November 19-21, 2025 Houston, Texas, United States

December 2-3, 2025 Philadelphia, Pennsylvania, United States

December 3-4, 2025 London, England, United Kingdom
December 8-11, 2025 Cold Spring Harbor, New York, United States

January 20-22, 2026 Boston, Massachusetts, United States

February 4-5, 2026 Cambridge, England, United Kingdom
May 10-13, 2026 St. Julian's, Malta
